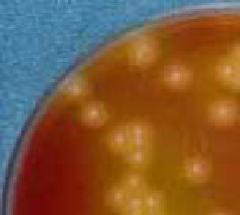

ここから本文です。
その他の食中毒菌検査
最終更新日 2024年4月2日
その他の食中毒菌
感染型や毒素型のどちらにも分類されないものです。
ウエルシュ菌
卵黄加CW寒天培地上のウェルシュ菌
自然界に広く分布し、土壌や水、ヒトや動物の腸内に常在しています。芽胞という殻を形成することがあり、100℃で1時間~6時間加熱しても生残することがあります。また、この菌は空気の薄い嫌気的な条件で増殖するため、カレーやシチューなどを大量に作った場合などに原因食品となりやすくなります。
検査法
卵黄加CW寒天培地に接種し、嫌気培養後、典型的コロニーをクックドミート培地を用いて増菌し、性状試験を行い確定します。
セレウス菌

NGKG寒天培地上のセレウス菌
土壌、塵埃などの自然界に広く分布し、普段は芽胞を形成し条件が整うと発芽します。熱に強く、食品の腐敗菌の一種です。
穀物などの農作物を原料とする食品が原因となることが多いです。
検査法
NGKG寒天培地に接種し、典型的なコロニーについて性状試験を行い確定します。
病原大腸菌(下痢原性大腸菌)
大腸菌(Escherichia coli)はヒトを含めた各種動物の腸内常在菌叢を構成する細菌の一種ですが、それら動物から排泄された糞便が、いろいろなものを汚染させる結果として、自然界に広く分布しています。
その中には病原大腸菌と総称されるヒトに下痢を起こす種類が存在し、代表的なものとして「O157」や「O26」などが知られています。
腸管出血性大腸菌はベロ毒素を産生し、溶血性尿毒症症候群(HUS)などの合併症を引き起こすことがある一方で、感染しても発症しない場合もあります。
予防としては手洗いを十分に行い、食材はよく洗い十分な加熱をしましょう(中心部が75℃で1分間以上)。
焼肉などでは、使用するトングや箸について生肉用と食べる用を分けるなど、取扱いに注意が必要です。また、井戸水は飲まないようにしましょう。
もしも感染した場合には、すぐに医師の診察を受け感染者の便による汚染が広がらないように注意しましょう。
このページへのお問合せ
医療局健康安全部中央卸売市場本場食品衛生検査所
電話:045-441-1153
電話:045-441-1153
ファクス:045-441-8009
メールアドレス:ir-honjo@city.yokohama.lg.jp
ページID:937-122-468







